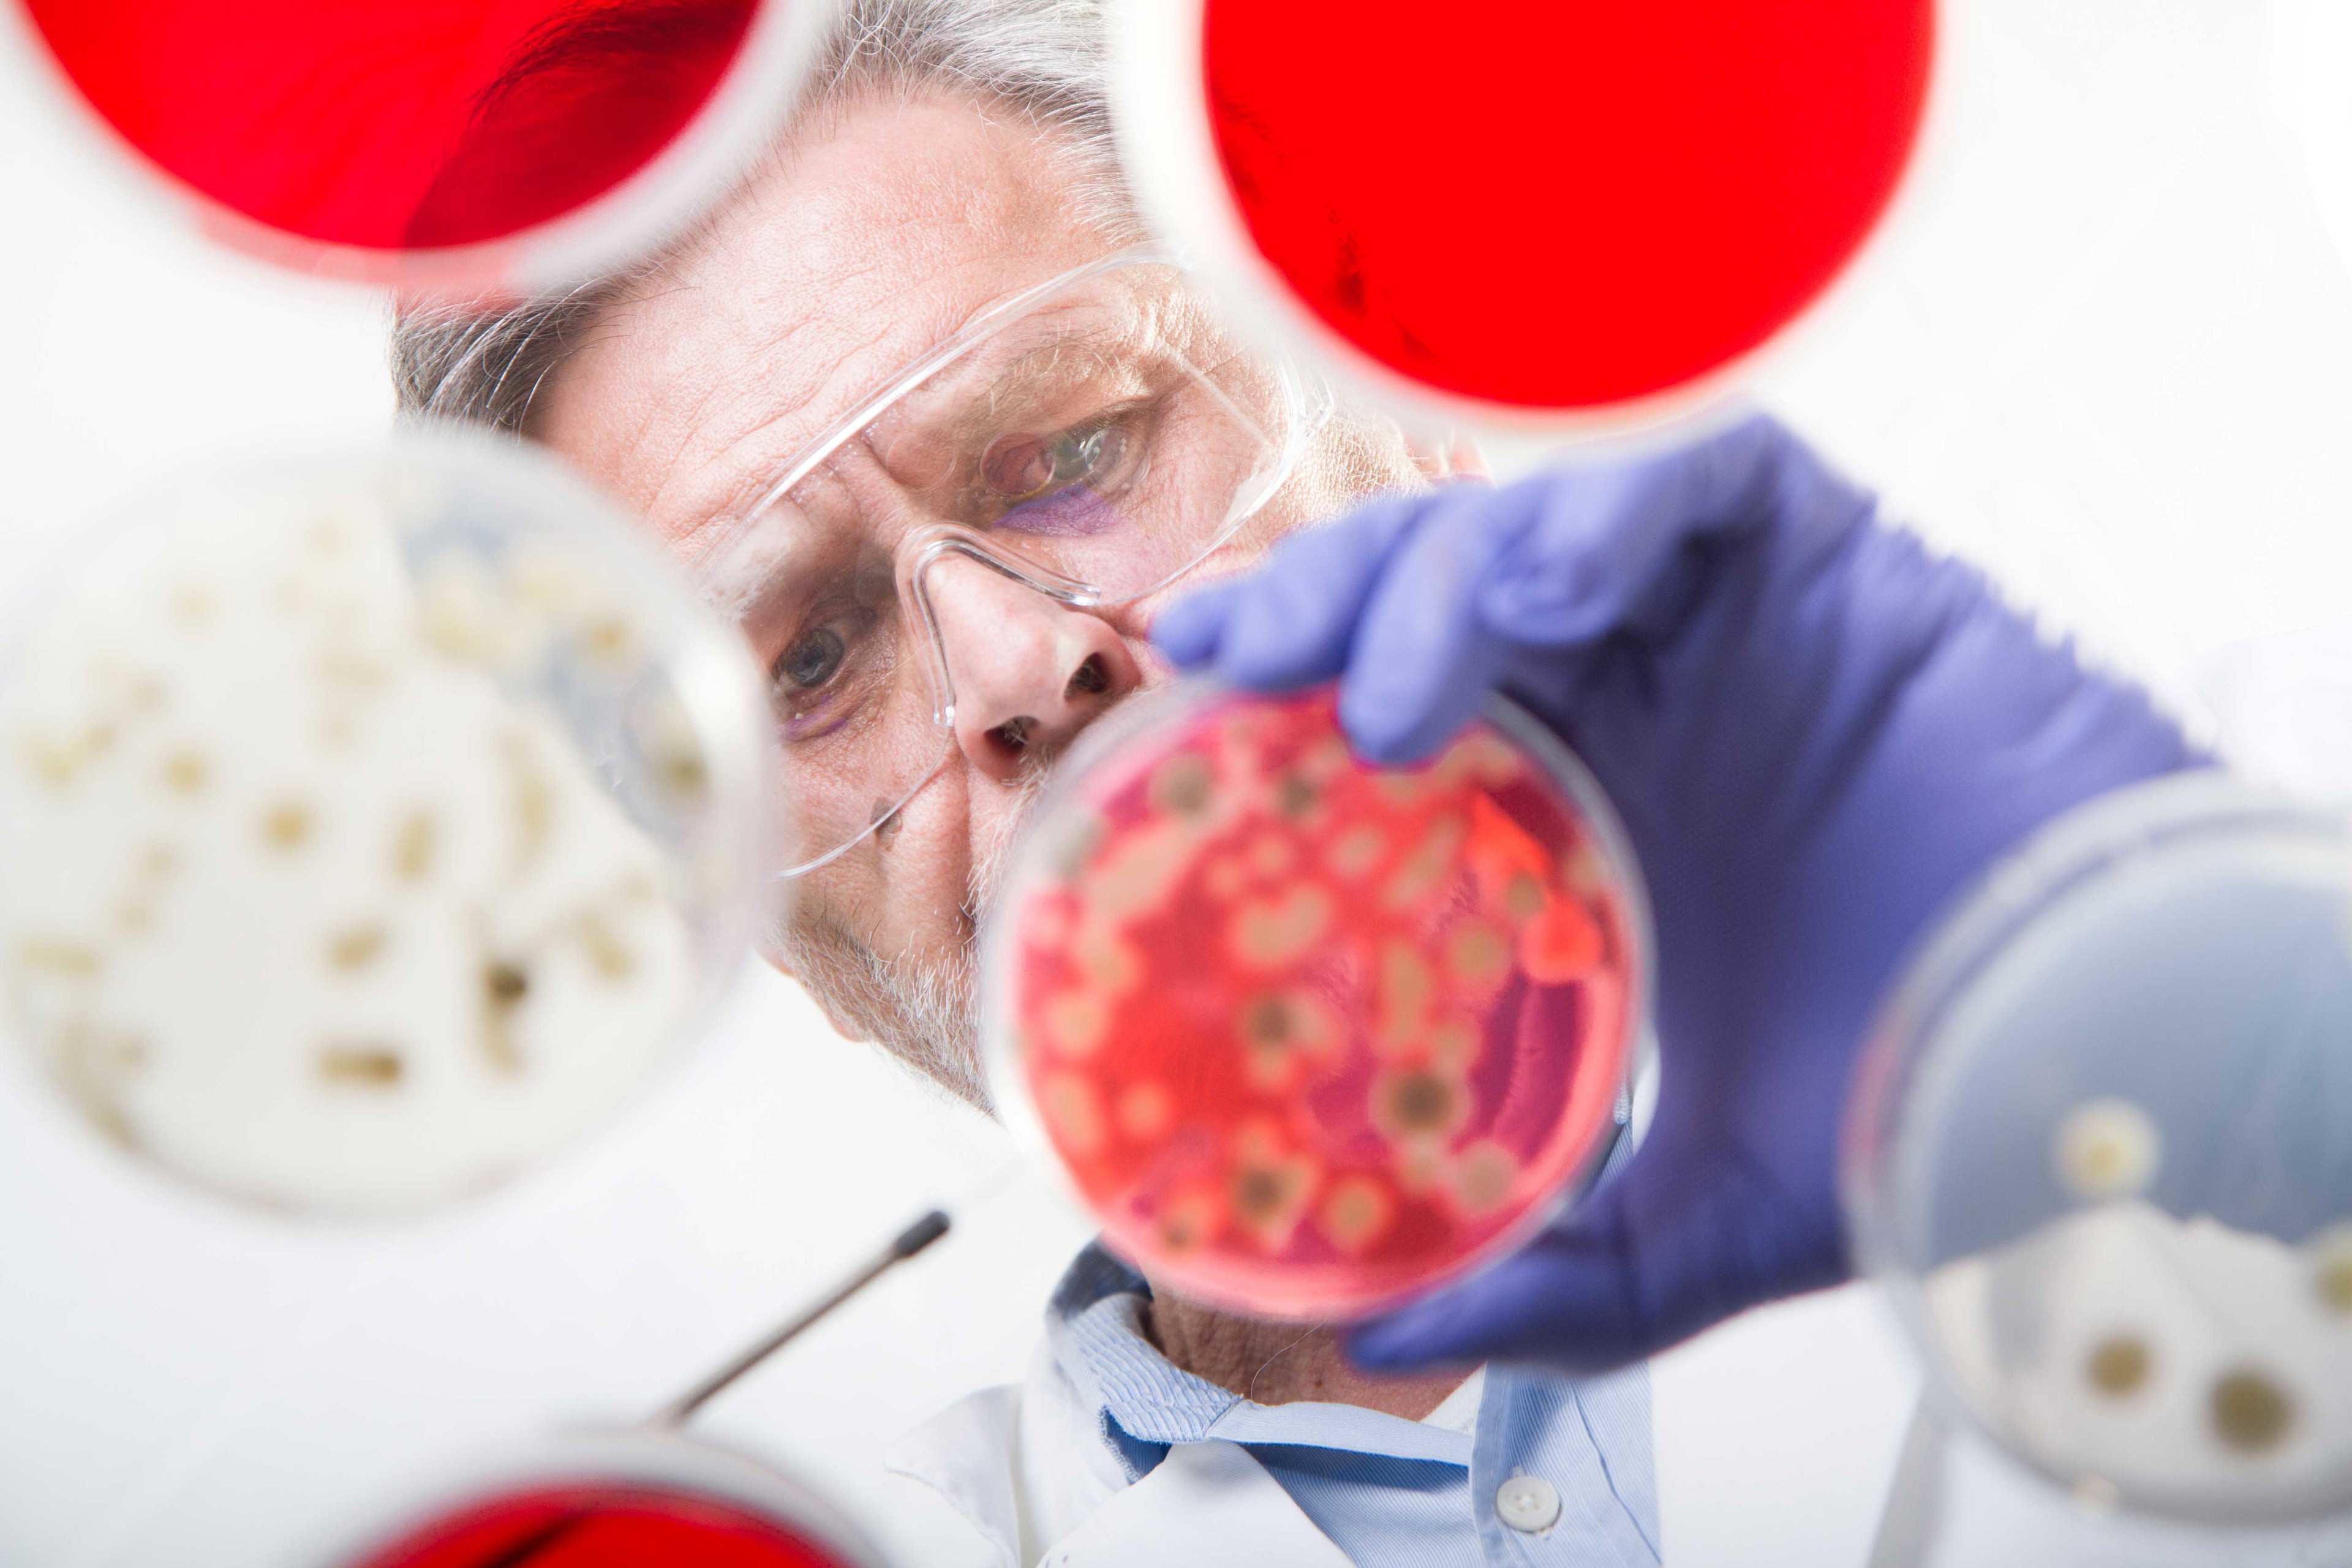
AMR_CATEGORY_PLATES.jpg

MASTDISCS® Antifungal
Explore MASTDISCS® Antifungal products
Fungal infections are an increasingly recognised threat to public health, with the World Health Organization's fungal priority pathogen list highlighting the urgent need for reliable antifungal susceptibility testing in clinical laboratories.
The MASTDISCS® Antifungal range provides a high quality, straightforward solution for the determination of susceptibility of common fungal pathogens using disc diffusion methodology, delivering the reliable and consistent results that clinical microbiology laboratories depend upon.
The range covers a comprehensive selection of clinically relevant antifungals, including fluconazole, amphotericin B, flucytosine and the recently introduced rezafungin, ensuring laboratories are equipped to test against both established and emerging treatment options.
Explore our Microbiology Solutions